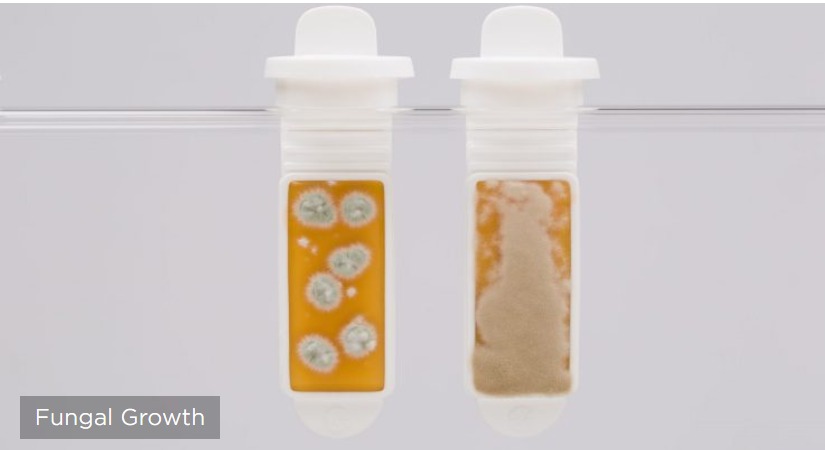

Dip Slides
₱ 0.00
Brand: ECHA Microbiology -UK
Dip Slides provide a semi-quantitative assessment of microbiological contamination that may be present in a water sample. This method can show what type ( bacterial / fungal) of microbial contaminant is present, as well as the extent of the contamination. TRUSTED + Dip Slides provide what is commonly known as a Total Viable Count (TVC), which indicates the extent of microbial growth in a Water Sample. Dip Slides can also differentiate between the types of contaminants that may be present (Bacteria, Fungi et al), and the overview they provide is considered semi-quantitative. INNOVATIVE + Anyone can easily use the kit, by simply dipping the slides into any given water-based sample. The Dip Slides can also be used for testing surfaces, and specific instructions are provided for this application. ACCURATE + The Dip Slides use the same principles as traditional culture methods, and can detect various levels of microbial contamination providing that the sample being tested is an aqueous sample. This test will NOT provide accurate results when testing Fuel or Oil Samples. DEPENDABLE + As well as being easy to use, Dip Slides are also very cost-effective. They provide a simple and cheap way of detecting microbes in water-based samples.
NOTE: No Exchange No Return Learn More
Warranty: Not applicable, except in cases of incorrect results from the chart. In such instances, we will replace the product upon receipt of proof in the form of videos and photos.
Quality comes first and our products deliver accurate results.